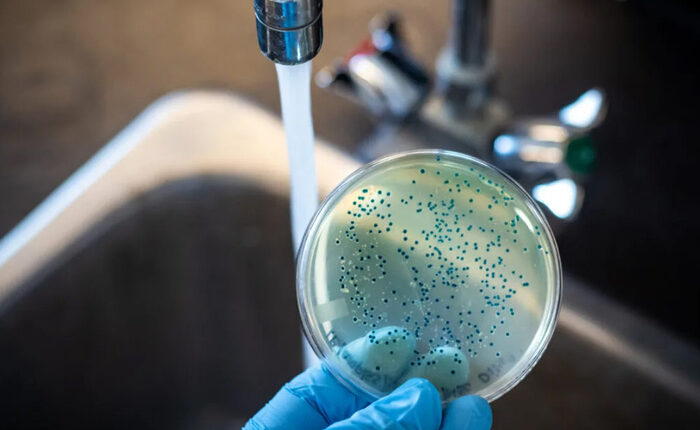

Alerta por la fiebre tifoidea
Autoridades investigan agua contaminada como la posible causa. Recomiendan hervir agua de pozo y limpiar tanques. La bacteria Salmonella Typhi puede ser mortal sin tratamiento.

Un brote de fiebre tifoidea encendió las alertas sanitarias en Ciudadela, partido Bonaerense de Tres de Febrero, donde se detectaron diez casos confirmados, seis de ellos con internación hospitalaria y dos en cuidados intensivos, según confirmó la Sociedad Argentina de Infectología. El Ministerio de Salud y autoridades epidemiológicas investigan el origen del contagio, que podría estar vinculado con agua contaminada en los tanques de edificios abastecidos con agua de pozo, luego de un prolongado corte del suministro regular.
Los casos fueron detectados entre el 9 de marzo y el 22 de abril, con pacientes que acudieron a centros médicos con fiebre alta, dolor abdominal, diarrea y deshidratación. La fiebre tifoidea es causada por la bacteria Salmonella Typhi y se transmite por consumo de agua o alimentos contaminados. Sin tratamiento, puede ser potencialmente mortal.
Las recomendaciones oficiales para prevenir contagios son usar agua segura para higiene y preparación de alimentos y en caso de consumirla de pozo, hervirla durante 3 minutos o desinfectar con lavandina apta ANMAT, siguiendo las dosis indicadas. También se deben limpiar periódicamente los tanques y verificar que estén tapados y sin filtraciones. El brote es monitoreado por el COE, mientras se refuerzan medidas de prevención en la zona afectada

Los comentarios están cerrados.